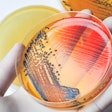

- Anitox Termin-8 supports poultry producers by controlling pathogens in feed and feed ingredients.
- Targeting resident Salmonella colonies within feed production facilities.
- Protecting feed from recontamination for up to 21 days, maintaining feed cleanliness until the point of consumption.
- Supporting bird performance by preventing disruption of a healthy microbiome by pathogens.

![Chickens Feeding Poultry House[1]](https://img.feedstrategy.com/files/base/wattglobalmedia/all/image/2023/05/chickens_feeding_poultry_house_1_.645eaecdca2a2.png?auto=format%2Ccompress&fit=crop&h=112&q=70&w=112)